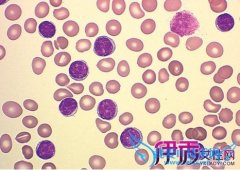

健康饮食
-
类别:健康饮食 发布时间:16-03-21 点击:1853
晚期潜伏梅毒怎么治疗晚期潜伏梅毒怎么治疗?晚期潜伏梅毒应根据病人的具体情况采取不同的治疗措施,下面为您介绍不同情况下晚期潜伏梅毒的不同治疗原则。潜伏梅毒中...
-
类别:健康饮食 发布时间:16-03-21 点击:1559
怎么避免阳痿男人要怎么避免阳痿?男人要怎么避免阳痿?既往将男子“性无能”泛称为“阳萎”,其科学界定不确切,并且带有歧视性贬义。直到1992年,决定用勃起功能障...
-
类别:健康饮食 发布时间:16-03-21 点击:1889
白细胞偏低会不会引起背痛白细胞旧称白血球,是血液中的一类细胞,通常被成为免疫细胞。血液中的白细胞是人体防御细菌入侵的巡逻兵,有人体“白色卫士”之称。白细胞...
-
类别:健康饮食 发布时间:16-03-21 点击:1818
生殖疱疹如何根治生殖器疱疹的治疗主要采用抗病毒治疗。治疗的目的主要是缓解症状,减轻疼痛,缩短病程及防止继发感染等。目前的治疗方法尚不能达到彻底清除病毒、消...
-
类别:健康饮食 发布时间:16-03-21 点击:2025
肝腹水能治愈吗肝腹水治疗情况主要看患者身体情况和治疗措施,大多数早发现早治疗的肝腹水患者病情可以得到控制,使肝腹水消退,身体达到基本康复。但是,如果出现肝...
-
类别:健康饮食 发布时间:16-03-21 点击:1722
老人喝加锌奶粉好不好营养专家提倡老年人要天天喝奶,在喝牛奶的同时,还需要额外补钙补锌吗?一些慢性病人喝什么样的奶好呢?配方奶可满足老年人生理需要“配方奶”...
-
类别:健康饮食 发布时间:16-03-21 点击:2029
忧郁症的症状表现有哪些抑郁症主要表现为情绪低落、思维迟缓、兴趣索然、精力丧失、自我评价过低,因而导致生活能力退弱和职业功能减低、工作效率下降。抑郁症前兆的...
-
类别:健康饮食 发布时间:16-03-21 点击:1650
患有子宫肌瘤子宫肌瘤作为女性生殖器中最常见的一种良性肿瘤。35岁以上的女性患有本病的约占到20%,多无症状,少数表现为阴道出血,腹部触及肿物以及压迫症状等。患...
-
类别:健康饮食 发布时间:16-03-21 点击:1984
颈部静脉窦是什么两栖类和爬行类的静脉窦开口于右心房。爬行类的静脉窦小,所以从心脏的外部不能识别。脊椎动物,在其心脏附近由大的静脉汇合所形成的血管腔。具有可...
-
类别:健康饮食 发布时间:16-03-21 点击:1673
身上长囊肿的原因身上长囊肿的原因是什么?任何年龄均发生,以青年时期头面、臂、背部发病多见,皮肤囊肿多发于青年时期,由于皮肤外伤所致,有时发病与外伤间隔多年...
-
类别:健康饮食 发布时间:16-03-21 点击:1767
肾炎平常饮食上应该吃些什么肾炎是一种比较常见的肾脏病,对患者带来一定的伤害,除了正规的治疗之外,还应该注意患者的饮食,合理的饮食对疾病的治疗及康复有一定的...
-
类别:健康饮食 发布时间:16-03-21 点击:1792
怎么让嗓子说话不累每个人都有适合自己说话的频率,方法就是将手指放在鼻背上,然后开口说话。当你的手指感受到鼻背有抖动时,说明此时你说话的频率是适合你的、、、...
-
类别:健康饮食 发布时间:16-03-21 点击:1739
女性外阴瘙痒外阴瘙痒是很常见的情况,很多女性因为外阴瘙痒这样的疾病伤害到身体,出现了外阴瘙痒了就需要关注很多这方面的疾病,引起外阴瘙痒的病因有哪些?下面就...
-
类别:健康饮食 发布时间:16-03-21 点击:1665
如何锻炼腰椎本练功方法适用于腰椎损伤性疾病(如腰椎间盘突出症、退行性腰椎炎、腰椎管狭窄症、腰椎弓裂合并脊椎滑脱、脊柱侧弯畸形等)的辅助治疗与康复期锻炼;健康...
-
类别:健康饮食 发布时间:16-03-21 点击:1596
对大豆过敏能吃其他豆吗对大豆过敏能吃其他豆吗?对大豆过敏,建议就所有的豆子都不要吃了。因为不一定哪类豆子就会引发你过敏。所以最好就不要吃了。食物过敏原包括...